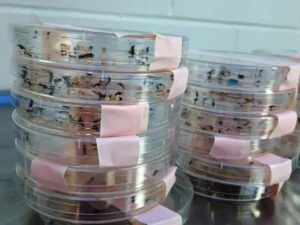
Mosquitoes in petri dishes. ©University of South Florida

Birds that have more of the stress hormone corticosterone are more likely to be bitten by mosquitoes that can carry West Nile virus, according to a new study.
“This particular study is the first chain linking the interaction between the virus, the mosquito and the bird,” said senior author of the study, Lynn (Marty) Martin, who is an associate professor at the University of South Florida.

Martin says it’s important to think of the disease as a process, with the first step being the virus finding its hosts, which, in this case, are birds. “We were looking at how stress hormones affect the contact rate of mosquitoes with birds,” he said. “Lo and behold, we found that stress hormones were pretty important in mosquitoes choosing which hosts to bite.”
As part of their study — recently published in the Proceedings of the Royal Society B — the researchers examined how the southern house mosquito — a vector of West Nile virus — chose to feed on zebra finches (Taeniopygia guttata) with altered stress hormones. The team first manipulated the hormone in the birds, releasing it into the blood stream at a certain rate. Then — and this was Martin’s favorite part of the study — they placed three different birds in a cage filled with mosquitoes: one bird with a small amount of the stress hormone, one with a bit more, and one without any hormone. They then introduced the mosquitoes at sundown when they’re most likely to bite and retrieved the bugs first thing in the morning.
Next, Martin and his colleagues collected the mosquitoes that had visibly blood-filled abdomens and extracted the blood from their guts to compare it with the blood from the birds. They found the stressed birds were twice as likely to be bitten by mosquitoes.
The team also video recorded the birds overnight and kept track of their defensive behaviors including things like flicking their wings and nipping at the mosquitoes. They found that the birds with the stress hormones were more defensive although it isn’t clear why that didn’t keep them from getting bitten. Martin speculates the stressed birds may have been so attractive to the mosquitoes that they were determined to keep trying to bite until they succeeded.
©University of South Florida
Martin says this research has implications for management of wildlife, particularly species that are infected by West Nile virus. Elevated levels of the hormone for a long period of time are responsible for these increases in mosquito bites, he says. These elevated levels may occur as a result of habitat manipulation, noise pollution, light pollution and other anthropogenic stressors in the wild.
Martin suggests that ecotourism might even exacerbate some of these issues, but the “jury is still out on that,” he said. “We don’t have a good handle yet on how much bird-watching, bird-feeding, and the like cause stress to animals.” He and his team plan to study this further outside of the lab and to look at how light pollution may be influencing West Nile virus dynamics.
Martin says this study is part of larger effort to understand how stress hormones affect West Nile in wildlife. “We’re trying to get the last couple of experiments done to discover all of the stages at which stress hormones might affect West Nile dynamics,” he said. “We want to know how stress affects the way birds deal with the virus, but we especially want to know how stress affects the transmission of virus from infected bird back into mosquitoes.”
Article by Dana Kobilinsky